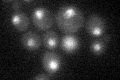
YGR246C
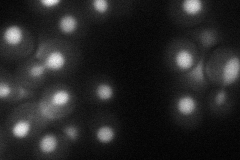
YGR246C
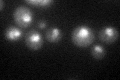
YGR246C

View description
TFIIIB B-related factor, one of three subunits of RNA polymerase III transcription initiation factor TFIIIB, binds TFIIIC and TBP and recruits RNA pol III to promoters, amino-terminal half is homologous to TFIIB
Localization:
Intensity:
Fold change:
Significance:
-
C’ GFP library in SD
nucleus28.28 -
N' NOP1pr-GFP in SD

nucleus95.9017 -
N' TEF2pr-mCherry in SD
nucleus30.4589 -
N' NATIVEpr-GFP in SD

nucleus36.3004 -
N' TEF2pr-VC and Cyto-VN in SD

nucleus30.5101 -
C’ GFP library in SD+DTT
nucleus26.240.92No -
C’ GFP library in SD+H2O2

nucleus29.811.05No -
C’ GFP library in Starvation Media

nucleus22.780.8No -
C’ GFP library on the background of Pup2-DaMP

nucleus -
C’ GFP library on the background of CCT mutant

nucleus28.34771.00203No
